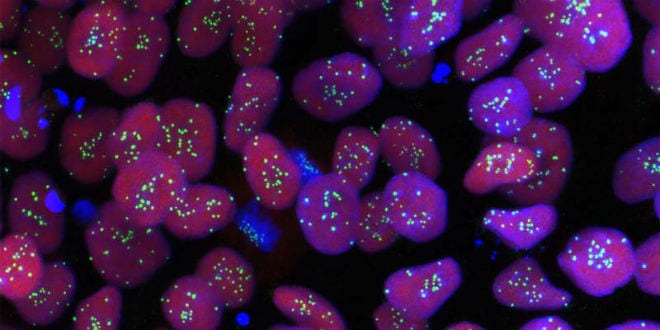

If it were possible for you to “order” a smarter or taller-than-average baby by pre-screening embryos for desired genetic traits via pre-implantation genetic diagnosis (PGD) before undergoing in-vitro fertilization (IVF), you would probably be wasting your time.
A group of Israeli researchers from the Hebrew University of Jerusalem who ran virtual experiments based on real-life genomic data found that embryo selections based on height or IQ have only modest benefits – for height, an increase of two or three centimeters, and for IQ, an additional two or three points above average. Their findings were published in the latest edition of the journal Cell under the title “Screening human embryos for polygenic traits have limited utility.”
It’s illegal to select embryos for intelligence or height in Israel, but, with Health Ministry approval, couples who have four or more children of a single-gender can ask for approval to undergo IVF to choose an embryo for the opposite sex.
In PGD, the selection of the embryo’s gender the embryo gender is carried out about 72 hours after fertilization by extracting one or two cells from the pre-implantation embryo.
The Health Ministry in Jerusalem states that “a medical purpose could be the prevention of severe congenital defects, which are gender-dependent. In extremely exceptional, rare and special cases and after receiving advance authorization from the National Commission on Infant Gender Selection, a legally married couple (or a single woman) are allowed to specify the gender of the fetus to be implanted in the uterus if they pay for the entire procedure.
The applicants must already have four children from their relationship and still do not have a child of the second gender, with the exception of extremely rare and exceptional cases and for special reasons which will be written into the commission’s resolution. This process does not leave the result to chance.
But ever since IVF became a reality and scientists began pre-screening embryos for genetic disorders, the fantasy of creating “designer babies” in which parents could select for a group of traits (blonde hair, blue eyes, male/female) took hold of the public’s imagination. These days, selecting embryos for eye color or sex are easy feats for a scientist to perform, as they involve only one or very few genes.
Dr. Shai Carmi at the university’s Braun School of Public Health and Community medicine looked into whether selecting embryos for other traits – albeit theoretical and illegal – would turn out as the parents desired.
“In the past five years, selecting embryos for particular traits has become easier and cheaper,” said Carmi. “While this technique is a tremendous help to parents with serious genetic diseases, it is still a highly controversial procedure when it’s used for non-life-threatening reasons where ethical questions of eugenics and unequal opportunities arise.”
The Hebrew University team wondered: “What would happen if we took 10 embryos from one pair of parents, rated each embryo for height or IQ and implanted embryos with the highest score?” They ran computer simulations using gene sequences from real people to create profiles of hypothetical embryos that would result from pairings of those people and predicted the adult height or IQ for each of the embryos based on the gene variants present in their genomes.
But the results showed that the advantages of choosing the embryos for desired treats were relatively small. For height, the gain was just three centimeters above the average embryo in the batch; for IQ, the gain was a measly three intelligence points. With five embryos to choose from, the gain was 2.5 centimeters and 2.5 IQ points. When the team widened the scope to see what would happen if they could choose from a batch of 50 embryos (a near-impossible biological feat for most couples)m the greatest gain was only 4.5 cm for height and 4.5 IQ points.
To corroborate their findings, the researchers also used real-world data to demonstrate that trait predictions based on currently known gene variants are not guaranteed. They looked at the genetics of 28 families with 10 or more adult-age children. Based on the genomic makeup of each child, they selected those with the top score for height. However, in three-quarters of the families, the child whom the scientists had “selected” was not the tallest sibling, even though their genomic data had predicted that they would be.
Carmi explained that “our current knowledge of the genetic makeup of certain traits may not be enough to generate a substantial increase in the desired traits in an embryo selection scenario. The crucial roles of nurture and unknown genetic factors are also at play.”
For those who argue that even nominal height and IQ improvements may warrant embryo selection, Carmi warns that not only are their desired outcomes not guaranteed, but they’re currently are pitfalls involved in such a procedure. The nature of gene variants is that one may select for one outcome but increase the risk for another, less-desirable outcome. For example, the group of genes that is linked to a high IQ is also somewhat linked to anorexia (self-starvation). In addition, attempts to select for several traits at once, for instance, an embryo that is tall AND smart AND thin, would make embryo selection far more complicated; an embryo that ranked highest for IQ may rank lowest for the desired body mass index.